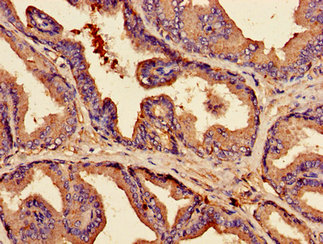

CLDN3 Antibody
-
中文名稱:CLDN3兔多克隆抗體
-
貨號:CSB-PA13119A0Rb
-
規(guī)格:¥440
-
圖片:
-
Western Blot
Positive WB detected in: Caco-2 whole cell lysate
All lanes: CLDN3 antibody at 3.5µg/ml
Secondary
Goat polyclonal to rabbit IgG at 1/50000 dilution
Predicted band size: 24 kDa
Observed band size: 24 kDa -
Immunohistochemistry of paraffin-embedded human prostate tissue using CSB-PA13119A0Rb at dilution of 1:100
-
-
其他:
產(chǎn)品詳情
-
產(chǎn)品名稱:Rabbit anti-Homo sapiens (Human) CLDN3 Polyclonal antibody
-
Uniprot No.:
-
基因名:
-
別名:CLDN3; C7orf1; CPETR2; Claudin-3; Clostridium perfringens enterotoxin receptor 2; CPE-R 2; CPE-receptor 2; Rat ventral prostate.1 protein homolog; hRVP1
-
宿主:Rabbit
-
反應(yīng)種屬:Human
-
免疫原:Recombinant Human Claudin-3 protein (181-220AA)
-
免疫原種屬:Homo sapiens (Human)
-
標(biāo)記方式:Non-conjugated
本頁面中的產(chǎn)品,CLDN3 Antibody (CSB-PA13119A0Rb),的標(biāo)記方式是Non-conjugated。對于CLDN3 Antibody,我們還提供其他標(biāo)記。見下表:
-
克隆類型:Polyclonal
-
抗體亞型:IgG
-
純化方式:>95%, Protein G purified
-
濃度:It differs from different batches. Please contact us to confirm it.
-
保存緩沖液:Preservative: 0.03% Proclin 300
Constituents: 50% Glycerol, 0.01M PBS, pH 7.4 -
產(chǎn)品提供形式:Liquid
-
應(yīng)用范圍:ELISA, WB, IHC
-
推薦稀釋比:
Application Recommended Dilution WB 1:500-1:5000 IHC 1:20-1:200 -
Protocols:
-
儲存條件:Upon receipt, store at -20°C or -80°C. Avoid repeated freeze.
-
貨期:Basically, we can dispatch the products out in 1-3 working days after receiving your orders. Delivery time maybe differs from different purchasing way or location, please kindly consult your local distributors for specific delivery time.
-
用途:For Research Use Only. Not for use in diagnostic or therapeutic procedures.
相關(guān)產(chǎn)品
靶點(diǎn)詳情
-
功能:Plays a major role in tight junction-specific obliteration of the intercellular space, through calcium-independent cell-adhesion activity.
-
基因功能參考文獻(xiàn):
- Claudin3 promoter methylation status (HR: 5.67; 95% CI: 2.2714.17) but not claudin3 expression was an independent predictor of survival. Claudin3 promoter hypermethylation reduces claudin3 expression and independently predicts poor prognosis. PMID: 29749528
- Immunohistochemical expression levels of cytoplasmic claudins 3 and 7 appear to be novel prognostic factors in triple-negative breast cancer. PMID: 29482498
- CLDN3 could be further evaluated as a novel biomarker for predicting the prognosis of lung squamous cell carcinoma (SqCC) and as a target for the treatment of lung SqCC in the future. PMID: 29511369
- We describe a novel workflow, completely covering the analysis of CLDN3 as an exemplary exosome-based biomarker for prostate cancer from in vitro profiling of cancer exosomes over in silico identification and in vitro retesting to clinical validation. PMID: 28396511
- Data indicate that CDH11, ICAM1 and CLDN3 were overexpressed in tumors when compared to normal esophagus, normal gastric and non-dysplastic Barrett's. PMID: 27363029
- Study provide first biochemically and clinically validated evidence to support a colorectal cancer-suppressive function of claudin-3 by serving as a conjoint rheostat for regulating Stat-3 and Wnt/beta-catenin-signaling. PMID: 28783170
- These tumor samples express CD44 protein at low rather than high levels. There is no correlation between CLDN3 gene expression and protein expression in these CPTAC samples; hence, the claudin-low subtype defined by gene expression is not the same group of tumors as that defined by low expression of CLDN3 protein. PMID: 28287265
- Increased expression of intestinal epithelial claudin-1 with downregulation of claudin-3 has been observed in intestinal inflammatory disorders. PMID: 28493289
- Data show that the charge of Lys65 in claudin 1 (Cldn1) and Glu158 in claudin 3 (Cldn3), and of Gln57 in claudin 5 (Cldn5) are necessary for tight junction (TJ) strand formation. PMID: 28415153
- Mislocalization claudin-3 to nucleus in colon cancer and mislocalization claudin-4 to nucleus in adenomas of the colon were detected for the first time. . PMID: 28295005
- Intracellular zinc has an essential role in the maintenance of the intestinal epithelial tight junction barrier through regulation of occludin proteolysis and claudin-3 transcription. PMID: 27151944
- permeability barriers and affected cell morphology, proliferation, migration, AKT signaling, and gene expression. When claudins are exogenously expressed, ARPE-19 more closely model native RPE. PMID: 27593915
- localization of Cldn3, Cldn7 and Cldn10 proteins in the different compartments of murine endometrium up to day 8.5 of pregnancy (dpc) as well as in human endometrium and first trimester decidua PMID: 26340953
- Cln-3 plays a vital role in TNF-modulated paracellular permeability in submandibular epithelium. PMID: 26148935
- Further in vitro studies suggested that the isolated MAbs possessed the desired binding properties for the detection or targeting of CLDN3. PMID: 25744656
- that Claudin-3 expression was restricted to the apical pole of ependymocytes in the subcommissural organ PMID: 24974365
- The expressions of MARVELD2, CLDN1 and CLDN3 mRNA were significantly lower in cholesteatoma tissue and may be involved in epithelium permeability. PMID: 25319490
- Univariate analyses indicated that the T stage, lymph node metastasis, the TNM stage, and the expression of claudin-3, beta-catenin, and vimentin were significant predictors for overall survival (OS). PMID: 25820701
- Data from live-cell imaging suggest at least two different cis-interaction interfaces within CLDN3 homopolymers as well as within CLDN1/CLDN3 heteropolymers. PMID: 25849148
- our findings demonstrated that CLDN3 is an epigenetically silenced metastasis suppressor gene in Hepatocellular carcinoma PMID: 25277196
- Study highlights a profound role for the choroid plexus in the pathogenesis of multiple sclerosis, and implies that CLDN3 may be regarded as a crucial and novel determinant of blood-cerebrospinal fluid barrier integrity PMID: 24356983
- Claudin 3 was expressed in all non-goblet columnar lined oesophagus, Barrett's oesophagus, high grade dysplasia and adenocarcinoma. PMID: 24290871
- Claudin-3 overexpression increases the malignant potential of colorectal cancer cells. PMID: 24069372
- folding and assembly of CLDN3 and CLDN5 into the tight junction are controlled by non-conserved residues in the transmembrane 3 and extracellular loop 2 segments PMID: 24478310
- Our comparative analysis of CLDN3 profile in breast and ovarian cancer clearly indicates organ specificity. PMID: 23529315
- Snail and Claudin-3 may play important roles in invasion and metastasis in NSCLC PMID: 23075682
- Claudin-3 expression in uterine luminal epithelium is stimulated by progesterone and suppressed by heparin-binding epidermal growth factor-like growth factor. PMID: 23909989
- High CLDN3 expression is associated with tumor growth and metastases. PMID: 23097631
- Dow-regulation of Claudin-3 is associated with the progression of early gastric adenocarcinomas. PMID: 22290341
- CLDN3 may have a role in ovarian cancer, and its inhibition by short hairpin RNA could be a treatment strategy. PMID: 21519794
- Analysis of staining intensities of CLDN 1 and 3 is useful as an auxiliary diagnostic and prognostic tool in patients with salivary gland mucoepidermoid carcinoma. PMID: 21184237
- demonstrate that claudin-3 alters the tight junction meshwork and seals the paracellular pathway against the passage of small ions of either charge and uncharged solutes PMID: 20655293
- Claudin-3 expression in Epstein-Barr virus-associated nasopharyngeal carcinoma was variable PMID: 20204275
- Increased expressions of CLDN 2 and 3 suggest structural changes of tight junction in coeliac disease which may be, at least in part, responsible for increased permeability and proliferation observed in coeliac disease. PMID: 20143085
- Here we show for the first time in both an experimental and clinical setting a strong relation between intestinal tight junction loss and urinary claudin-3 levels PMID: 19525861
- Airway tight junctions are regulated by claudin interactions that confer the selectivity of the junction. PMID: 12909588
- up-regulation of DDR1, CLDN3, and epithelial cell adhesion molecule are early events in the development of epithelial ovarian cancer PMID: 15240533
- in breast tissue, CLDN3 expression is similar in tumours and surrounding normal tissue, as demonstrated by immunohistochemistry and real-time PCR PMID: 15743508
- claudin-3 phosphorylation by PKA may provide a mechanism for the disruption of tight junctions in ovarian cancer PMID: 15905176
- The gene expression profile of hepatic stem cells throughout life consists of high levels of expression of claudin-3 (CLDN-3). PMID: 16627685
- Claudin tight junction proteins in endoscopy biopsy samples showed Barrett's metaplasia contains more claudin-2 and claudin-3 than found in normal esophageal mucosa, but markedly lower claudins 1 and 5, indicating very different tight junction barriers. PMID: 17103306
- Overexpression of claudin-3 is associated with uterine serous papillary carcinoma PMID: 17326053
- When compared, small-cell-lung cancers, carcinoid tumors, and adenocarcinomas revealed significant differences re: CLDN3 expression. PMID: 17418912
- CLDN3 overexpression can be used as a prognostic indicator in ovarian serous carcinomas and it may be a promising target for antibody-based therapy of ovarian carcinomas. PMID: 17647191
- siRNA-mediated knockdown of Sp1 led to a significant decrease of CLDN3 expression at both the mRNA and protein levels, demonstrating a crucial role for this transcription factor in the regulation of CLDN3. PMID: 17986852
- Claudin-3 and claudin-7 expression in effusions independently predicts poor survival in ovarian cancer. PMID: 18439941
- claudins 1 and 3 had a significant effect on overall survival in patients with urothelial carcinoma of the upper urinary tract. PMID: 18550469
- This is the first study to demonstrate that claudin-3 is involved in the barrier function of gastric epithelial cells and that rebamipide abolishes the H2O2-induced decrease in claudin-3 protein. PMID: 18774778
- For the first time this study proves the presence of Claudin-1, Claudin-3 and Claudin-5 in ECV304 (obtained from ECACC) cell layers and the inducibility of their expression by glioma-conditioned media. PMID: 18817843
- Using a panel of four genes (AHRR, p16INK4a, MT1G, and CLDN3) resulted in sensitivity and specificity of 50% and 68%, respectively and may have utility for early detection of esophageal squamous dysplasia and early ESCC. PMID: 19137073
顯示更多
收起更多
-
相關(guān)疾病:CLDN3 is located in the Williams-Beuren syndrome (WBS) critical region. WBS results from a hemizygous deletion of several genes on chromosome 7q11.23, thought to arise as a consequence of unequal crossing over between highly homologous low-copy repeat sequences flanking the deleted region.
-
亞細(xì)胞定位:Cell junction, tight junction. Cell membrane; Multi-pass membrane protein.
-
蛋白家族:Claudin family
-
數(shù)據(jù)庫鏈接:
Most popular with customers
-
-
YWHAB Recombinant Monoclonal Antibody
Applications: ELISA, WB, IHC, IF, FC
Species Reactivity: Human, Mouse, Rat
-
-
-
-
-
-